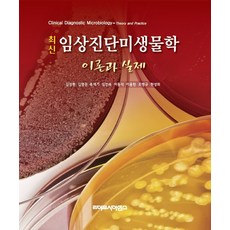
최신미생물학실험

오늘도 행복한 하루 보내셨나요? ♥
IT를 좋아하는 꼬르데 인사드립니다♡
오늘 블로그에서는
최신미생물학실험에 관해 알아볼께요.
【최신미생물학실험 HIT상품 핵심 리뷰】
< 스토리 순서 >
① 신문기사 ② 관련영상 ③ 대박순위
☞ 최신미생물학실험 관련 SNS 언론소식 모음 ☜
[인터뷰] 스투첸 다이슨 미생물학자 “반려동물도 알레르기 유발… 펫 전용 툴로 털 관리하고 자주 청소해야”
서울대병원 연구진, 뇌손상 치료용 나노자임 개발 外
북의 "전민과학기술인재화" (1) ― 초중등 과학기술 교육 강화
☞ 관련 영상 ☜
☞ 추천인기 리스트 ☜
|

|
2위
(고려의학) 2017년 08월판 최신 미생물학실험 [ 제2판 ], 1권으로 (선택시 취소불가)
33,700원
[ 제품 및 후기보기 ]
|
|

|
9위
(고려의학) 2017년 08월판 최신 미생물학실험 [ 제2판 ], 분철안함
31,900원
[ 제품 및 후기보기 ]
|
|
|
10위
최신 임상진단미생물학: 이론과 실제, 김성현,김영권,류재기 저, 라이프사이언스
55,000원
[ 제품 및 후기보기 ]
|
|

|
18위
(라이프사이언스) 김성현 최신임상진단미생물학 이론과 실제, 2권으로 (선택시 취소불가)
60,900원
[ 제품 및 후기보기 ]
|
인플루언서들이 열광할 만한 최신미생물학실험 상품들을 한눈에 보이게 리스트업해보았습니다.
가격변동, 품절 등의 사유가 발생할수도 있으니 홈페이지 방문하여 결정하시구요.
앞으로도 좋은 제품을 공유하기 위해 노력하겠습니다.
오늘 하루도 즐겁고 행복하게 보내시기를 바랍니다.
지금 읽은 글은 파트너스 일환으로 일정액의 수익금을 지급가능해요 ^ㅠ^
|